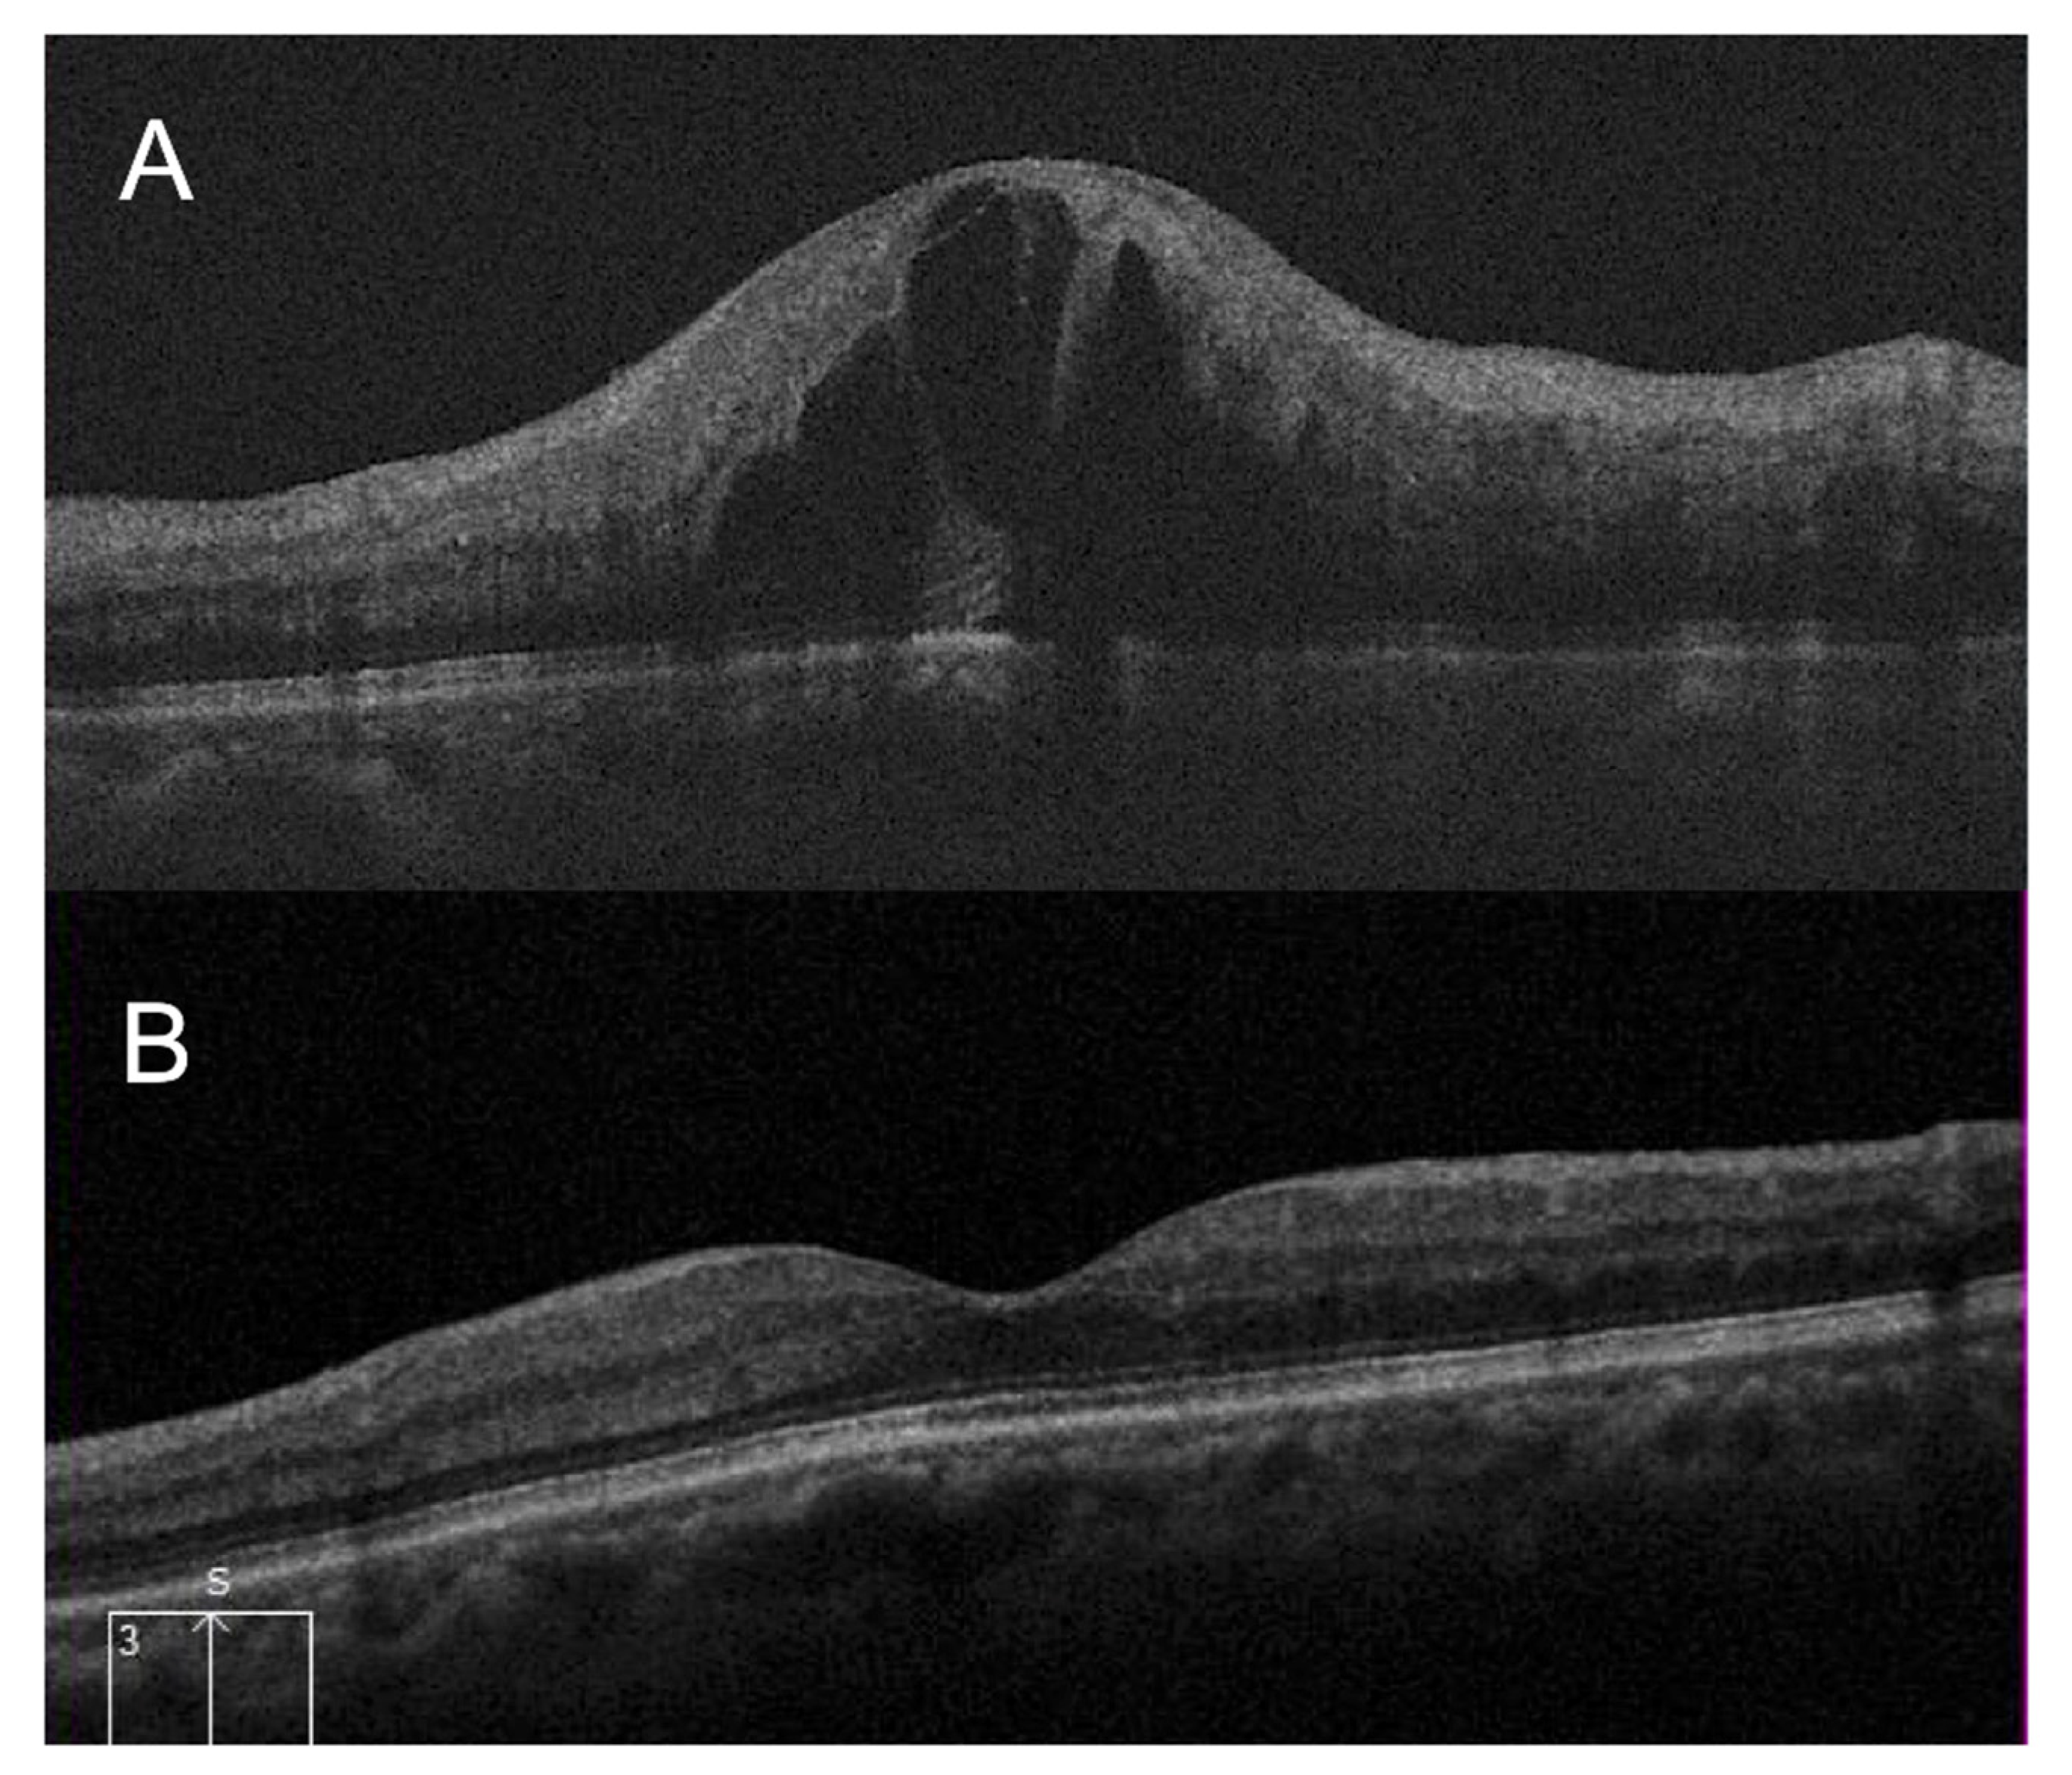
Jcm 11 04139 g002

Visual Functions Affecting Vision-Related Quality of Life Following Intravitreal Ranibizumab Therapy for Central Retinal Vein Occlusion
Abstract
:1. Introduction
2. Materials and Methods
2.1. Assessments
2.2. Contrast Sensitivity
2.3. Metamorphopsia
2.4. Aniseikonia
2.5. Stereopsis
2.6. Vision-Related Quality of Life
2.7. Spectral-Domain Optical Coherence Tomography
2.8. Treatment
2.9. Statistical Analyses
3. Results
3.1. Participants
3.2. Changes in Visual Functions
Representative Cases
4. Discussion
5. Conclusions
Author Contributions
Funding
Institutional Review Board Statement
Informed Consent Statement
Data Availability Statement
Conflicts of Interest
References
- Wong, T.Y.; Scott, I.U. Retinal-Vein Occlusion. N. Engl. J. Med. 2010, 363, 2135–2144. [Google Scholar] [CrossRef] [PubMed]
- Campochiaro, P.A.; Brown, D.M.; Awh, C.C.; Lee, S.Y.; Gray, S.; Saroj, N.; Murahashi, W.Y.; Rubio, R.G. Sustained Benefits from Ranibizumab for Macular Edema following Central Retinal Vein Occlusion: Twelve-Month Outcomes of a Phase III Study. Ophthalmology 2011, 118, 2041–2049. [Google Scholar] [CrossRef] [PubMed]
- Korobelnik, J.-F.; Holz, F.G.; Roider, J.; Ogura, Y.; Simader, C.; Schmidt-Erfurth, U.; Lorenz, K.; Honda, M.; Vitti, R.; Berliner, A.J.; et al. Intravitreal Aflibercept Injection for Macular Edema Resulting from Central Retinal Vein Occlusion. Ophthalmology 2013, 121, 202–208. [Google Scholar] [CrossRef] [PubMed] [Green Version]
- Manabe, K.; Osaka, R.; Nakano, Y.; Takasago, Y.; Fujita, T.; Shiragami, C.; Hirooka, K.; Muraoka, Y.; Tsujikawa, A. Metamorphopsia associated with central retinal vein occlusion. PLoS ONE 2017, 12, e0186737. [Google Scholar] [CrossRef] [PubMed]
- Murakami, T.; Okamoto, F.; Sugiura, Y.; Morikawa, S.; Okamoto, Y.; Hiraoka, T.; Oshika, T. Contrast sensitivity and quality of life following intravitreal ranibizumab injection for central retinal vein occlusion. Br. J. Ophthalmol. 2021, 1–7. [Google Scholar] [CrossRef] [PubMed]
- Okamoto, F.; Tomioka, M.; Murakami, T.; Morikawa, S.; Sugiura, Y.; Hiraoka, T.; Oshika, T. Relationship between stereopsis and vision-related quality of life following intravitreal ranibizumab injections for central retinal vein occlusion. Sci. Rep. 2021, 11, 20475. [Google Scholar] [CrossRef] [PubMed]
- Okamoto, F.; Okamoto, Y.; Hiraoka, T.; Oshika, T. Effect of Vitrectomy for Epiretinal Membrane on Visual Function and Vision-Related Quality of Life. Am. J. Ophthalmol. 2009, 147, 869–874. [Google Scholar] [CrossRef] [PubMed] [Green Version]
- Khanna, R.K.; Pichard, T.; Pasco, J.; Dorvault, M.; Cook, A.-R.; Pisella, P.-J.; Arsene, S. Monocular and binocular visual parameters associated to vision-related quality of life in patients with epiretinal membrane: A Prospective Cohort. Graefe’s Arch. Clin. Exp. Ophthalmol. 2021, 259, 1723–1730. [Google Scholar] [CrossRef] [PubMed]
- Fukuda, S.; Okamoto, F.; Yuasa, M.; Kunikata, T.; Okamoto, Y.; Hiraoka, T.; Oshika, T. Vision-related quality of life and visual function in patients undergoing vitrectomy, gas tamponade and cataract surgery for macular hole. Br. J. Ophthalmol. 2009, 93, 1595–1599. [Google Scholar] [CrossRef] [PubMed] [Green Version]
- Ng, H.; Vermeer, K.A.; van Meurs, J.C.; La Heij, E.C. Visual Acuity Inadequately Reflects Vision-Related Quality of Life in Patients After Macula-Off Retinal Detachment Surgery. Investig. Opthalmol. Vis. Sci. 2020, 61, 34. [Google Scholar] [CrossRef] [PubMed]
- Deramo, V.A. Vision-Related Quality of Life in People With Central Retinal Vein Occlusion Using the 25-Item National Eye Institute Visual Function Questionnaire. Arch. Ophthalmol. 2003, 121, 1297–1302. [Google Scholar] [CrossRef] [PubMed] [Green Version]
- Murakami, T.; Okamoto, F.; Sugiura, Y.; Okamoto, Y.; Hiraoka, T.; Oshika, T. Changes in aniseikonia and influencing-factors following successful macula-off retinal detachment surgery. Sci. Rep. 2019, 9, 11588. [Google Scholar] [CrossRef] [PubMed]
- Mangione, C.M.; Lee, P.; Gutierrez, P.R.; Spritzer, K.; Berry, S.; Hays, R.D. Development of the 25-list-item National Eye Institute Visual Function Questionnaire. Arch. Ophthalmol. 2001, 119, 1050–1058. [Google Scholar] [CrossRef] [PubMed]
- Okamoto, F.; Okamoto, Y.; Fukuda, S.; Hiraoka, T.; Oshika, T. Vision-Related Quality of Life and Visual Function after Vitrectomy for Various Vitreoretinal Disorders. Investig. Opthalmol. Vis. Sci. 2010, 51, 744–751. [Google Scholar] [CrossRef] [PubMed]
- Fraser, M.L.; Meuleners, L.B.; Lee, A.H.; Ng, J.Q.; Morlet, N. Vision, quality of life and depressive symptoms after first eye cataract surgery. Psychogeriatrics 2013, 13, 237–243. [Google Scholar] [CrossRef] [PubMed]
- Datta, S.; Foss, A.J.E.; Grainge, M.J.; Gregson, R.M.; Zaman, A.; Masud, T.; Osborn, F.; Harwood, R.H. The Importance of Acuity, Stereopsis, and Contrast Sensitivity for Health-Related Quality of Life in Elderly Women with Cataracts. Investig. Opthalmol. Vis. Sci. 2008, 49, 1–6. [Google Scholar] [CrossRef] [PubMed] [Green Version]
- Acosta-Rojas, E.R.; Comas, M.; Sala, M.; Castells, X. Association Between Visual Impairment and Patient-Reported Visual Disability at Different Stages of Cataract Surgery. Ophthalmic Epidemiol. 2006, 13, 299–307. [Google Scholar] [CrossRef] [PubMed]
- Rahi, J.S.; Cumberland, P.M.; Peckham, C.S. Visual Impairment and Vision-Related Quality of Life in Working-Age Adults: Findings in the 1958 British Birth Cohort. Ophthalmology 2009, 116, 270–274. [Google Scholar] [CrossRef] [PubMed]
- Okamoto, F.; Sugiura, Y.; Okamoto, Y.; Hiraoka, T.; Oshika, T. Time Course of Changes in Aniseikonia and Foveal Microstructure after Vitrectomy for Epiretinal Membrane. Ophthalmology 2014, 121, 2255–2260. [Google Scholar] [CrossRef] [PubMed]

| Number of Eyes | 23 |
|---|---|
| Age (years) | 72.2 ± 11.1 |
| Sex (men/women) | 13/10 |
| BCVA of the affected eye at baseline (logMAR) | 0.79 ± 0.56 |
| LCS of the affected eye at baseline (letters) | 7.7 ± 7.7 |
| Severity of metamorphopsia of the affected eye at baseline (degree) | 0.2 ± 0.3 |
| Amount of aniseikonia at baseline (%) | 0.1 ± 2.6 |
| Titmus Stereo Test value at baseline (log) | 3.2 ± 0.7 |
| TNO stereotest value at baseline (log) | 3.3 ± 0.6 |
| BCVA of the fellow eye (logMAR) | 0.01 ± 0.13 |
| LCS of the fellow eye (letters) | 21.1 ± 3.3 |
| Central foveal thickness at baseline (µm) | 771 ± 319 |
| Baseline | 3 M | 6 M | 12 M | |
|---|---|---|---|---|
| Best-corrected visual acuity (logMAR) | 0.79 ± 0.56 | 0.43 ± 0.49 | 0.51 ± 0.51 | 0.59 ± 0.61 |
| p value (from preoperative logMAR BCVA) | 0.001 *** | 0.005 ** | 0.038 * | |
| LCS (letters) | 7.7 ± 7.7 | 14.4 ± 7.6 | 13.0 ± 7.4 | 12.4 ± 9.0 |
| p value (from LCS at baseline) | 0.001 *** | 0.001 *** | 0.031 * | |
| Severity of metamorphopsia (degree) | 0.2 ± 0.3 | 0.3 ± 0.6 | 0.4 ± 0.5 | 0.3 ± 0.5 |
| p value (from severity of metamorphopsia at baseline) | 0.203 | 0.247 | 0.582 | |
| Amount of aniseikonia (%) | 0.1 ± 2.6 | −0.6 ± 1.6 | −1.0 ± 2.3 | 0.2 ± 0.9 |
| p value (from amount of aniseikonia at baseline) | 0.292 | 0.283 | 0.138 | |
| TST value (log) | 3.2 ± 0.7 | 2.7 ± 0.8 | 2.7 ± 0.8 | 2.7 ± 0.8 |
| p value (from TST value at baseline) | 0.001 *** | 0.008 ** | 0.023 * | |
| TNO stereotest value (log) | 3.3 ± 0.6 | 2.9 ± 0.7 | 2.9 ± 0.7 | 2.8 ± 0.8 |
| p value (from TNO stereotest value at baseline) | 0.003 *** | 0.009 ** | 0.012 * | |
| VFQ-25 composite score | 62.6 ± 16.9 | 70.6 ± 15.6 | 72.2 ± 15.8 | 74.3 ± 14.6 |
| p value (from VFQ-25 composite score at baseline) | 0.003 *** | 0.002 *** | 0.002 ** | |
| CFT (µm) | 771 ± 319 | 181 ± 58 | 361 ± 303 | 308 ± 259 |
| p value (from CFT at baseline) | 0.001 *** | 0.001 *** | 0.001 *** |
| Simple Regression Analysis | Multiple Regression Analyses | |||
|---|---|---|---|---|
| R | p | Standard β | p | |
| BCVA of the affected eye | −0.184 | 0.412 | 0.126 | 0.576 |
| BCVA of the fellow eye | −0.459 | 0.032 * | −0.568 | 0.011 † |
| LCS of the affected eye | 0.303 | 0.181 | 0.038 | 0.871 |
| LCS of the fellow eye | 0.364 | 0.115 | 0.138 | 0.671 |
| Severity of metamorphopsia of the affected eye | −0.047 | 0.835 | −0.076 | 0.182 |
| Amount of aniseikonia | 0.268 | 0.229 | −0.271 | 0.182 |
| Titmus Stereo Test value | −0.450 | 0.036 * | −0.149 | 0.515 |
| TNO stereotest value | −0.419 | 0.052 | −0.057 | 0.815 |
| Simple Regression Analysis | Multiple Regression Analyses | |||
|---|---|---|---|---|
| R | p | Standard β | p | |
| BCVA of the affected eye | −0.554 | 0.021 * | 0.076 | 0.772 |
| BCVA of the fellow eye | −0.687 | 0.002 ** | −0.527 | 0.005 †† |
| LCS of the affected eye | 0.517 | 0.033 * | 0.230 | 0.580 |
| LCS of the fellow eye | 0.579 | 0.015 * | −0.016 | 0.950 |
| Severity of metamorphopsia of the affected eye | −0.223 | 0.390 | −0.224 | 0.142 |
| Amount of aniseikonia | 0.288 | 0.263 | −0.294 | 0.075 |
| Titmus Stereo Test value | −0.419 | 0.094 | 0.209 | 0.468 |
| TNO stereotest value | −0.660 | 0.004 ** | −0.519 | 0.01 † |
| Changes in the VFQ-25 Composite Score | ||
|---|---|---|
| R | p | |
| Changes in best-corrected visual acuity | −0.068 | 0.796 |
| Changes in letter contrast sensitivity | 0.505 | 0.039 * |
| Changes in severity of metamorphopsia | 0.126 | 0.629 |
| Changes in amount of aniseikonia | 0.021 | 0.937 |
| Changes in Titmus Stereo Test value | −0.443 | 0.075 |
| Changes in TNO stereotest value | −0.443 | 0.075 |
Publisher’s Note: MDPI stays neutral with regard to jurisdictional claims in published maps and institutional affiliations. |
© 2022 by the authors. Licensee MDPI, Basel, Switzerland. This article is an open access article distributed under the terms and conditions of the Creative Commons Attribution (CC BY) license (https://creativecommons.org/licenses/by/4.0/).
Share and Cite
Murakami, T.; Okamoto, F.; Sugiura, Y.; Morikawa, S.; Okamoto, Y.; Hiraoka, T.; Oshika, T. Visual Functions Affecting Vision-Related Quality of Life Following Intravitreal Ranibizumab Therapy for Central Retinal Vein Occlusion. J. Clin. Med. 2022, 11, 4139. https://doi.org/10.3390/jcm11144139
Murakami T, Okamoto F, Sugiura Y, Morikawa S, Okamoto Y, Hiraoka T, Oshika T. Visual Functions Affecting Vision-Related Quality of Life Following Intravitreal Ranibizumab Therapy for Central Retinal Vein Occlusion. Journal of Clinical Medicine. 2022; 11(14):4139. https://doi.org/10.3390/jcm11144139
Chicago/Turabian StyleMurakami, Tomoya, Fumiki Okamoto, Yoshimi Sugiura, Shohei Morikawa, Yoshifumi Okamoto, Takahiro Hiraoka, and Tetsuro Oshika. 2022. "Visual Functions Affecting Vision-Related Quality of Life Following Intravitreal Ranibizumab Therapy for Central Retinal Vein Occlusion" Journal of Clinical Medicine 11, no. 14: 4139. https://doi.org/10.3390/jcm11144139
APA StyleMurakami, T., Okamoto, F., Sugiura, Y., Morikawa, S., Okamoto, Y., Hiraoka, T., & Oshika, T. (2022). Visual Functions Affecting Vision-Related Quality of Life Following Intravitreal Ranibizumab Therapy for Central Retinal Vein Occlusion. Journal of Clinical Medicine, 11(14), 4139. https://doi.org/10.3390/jcm11144139







